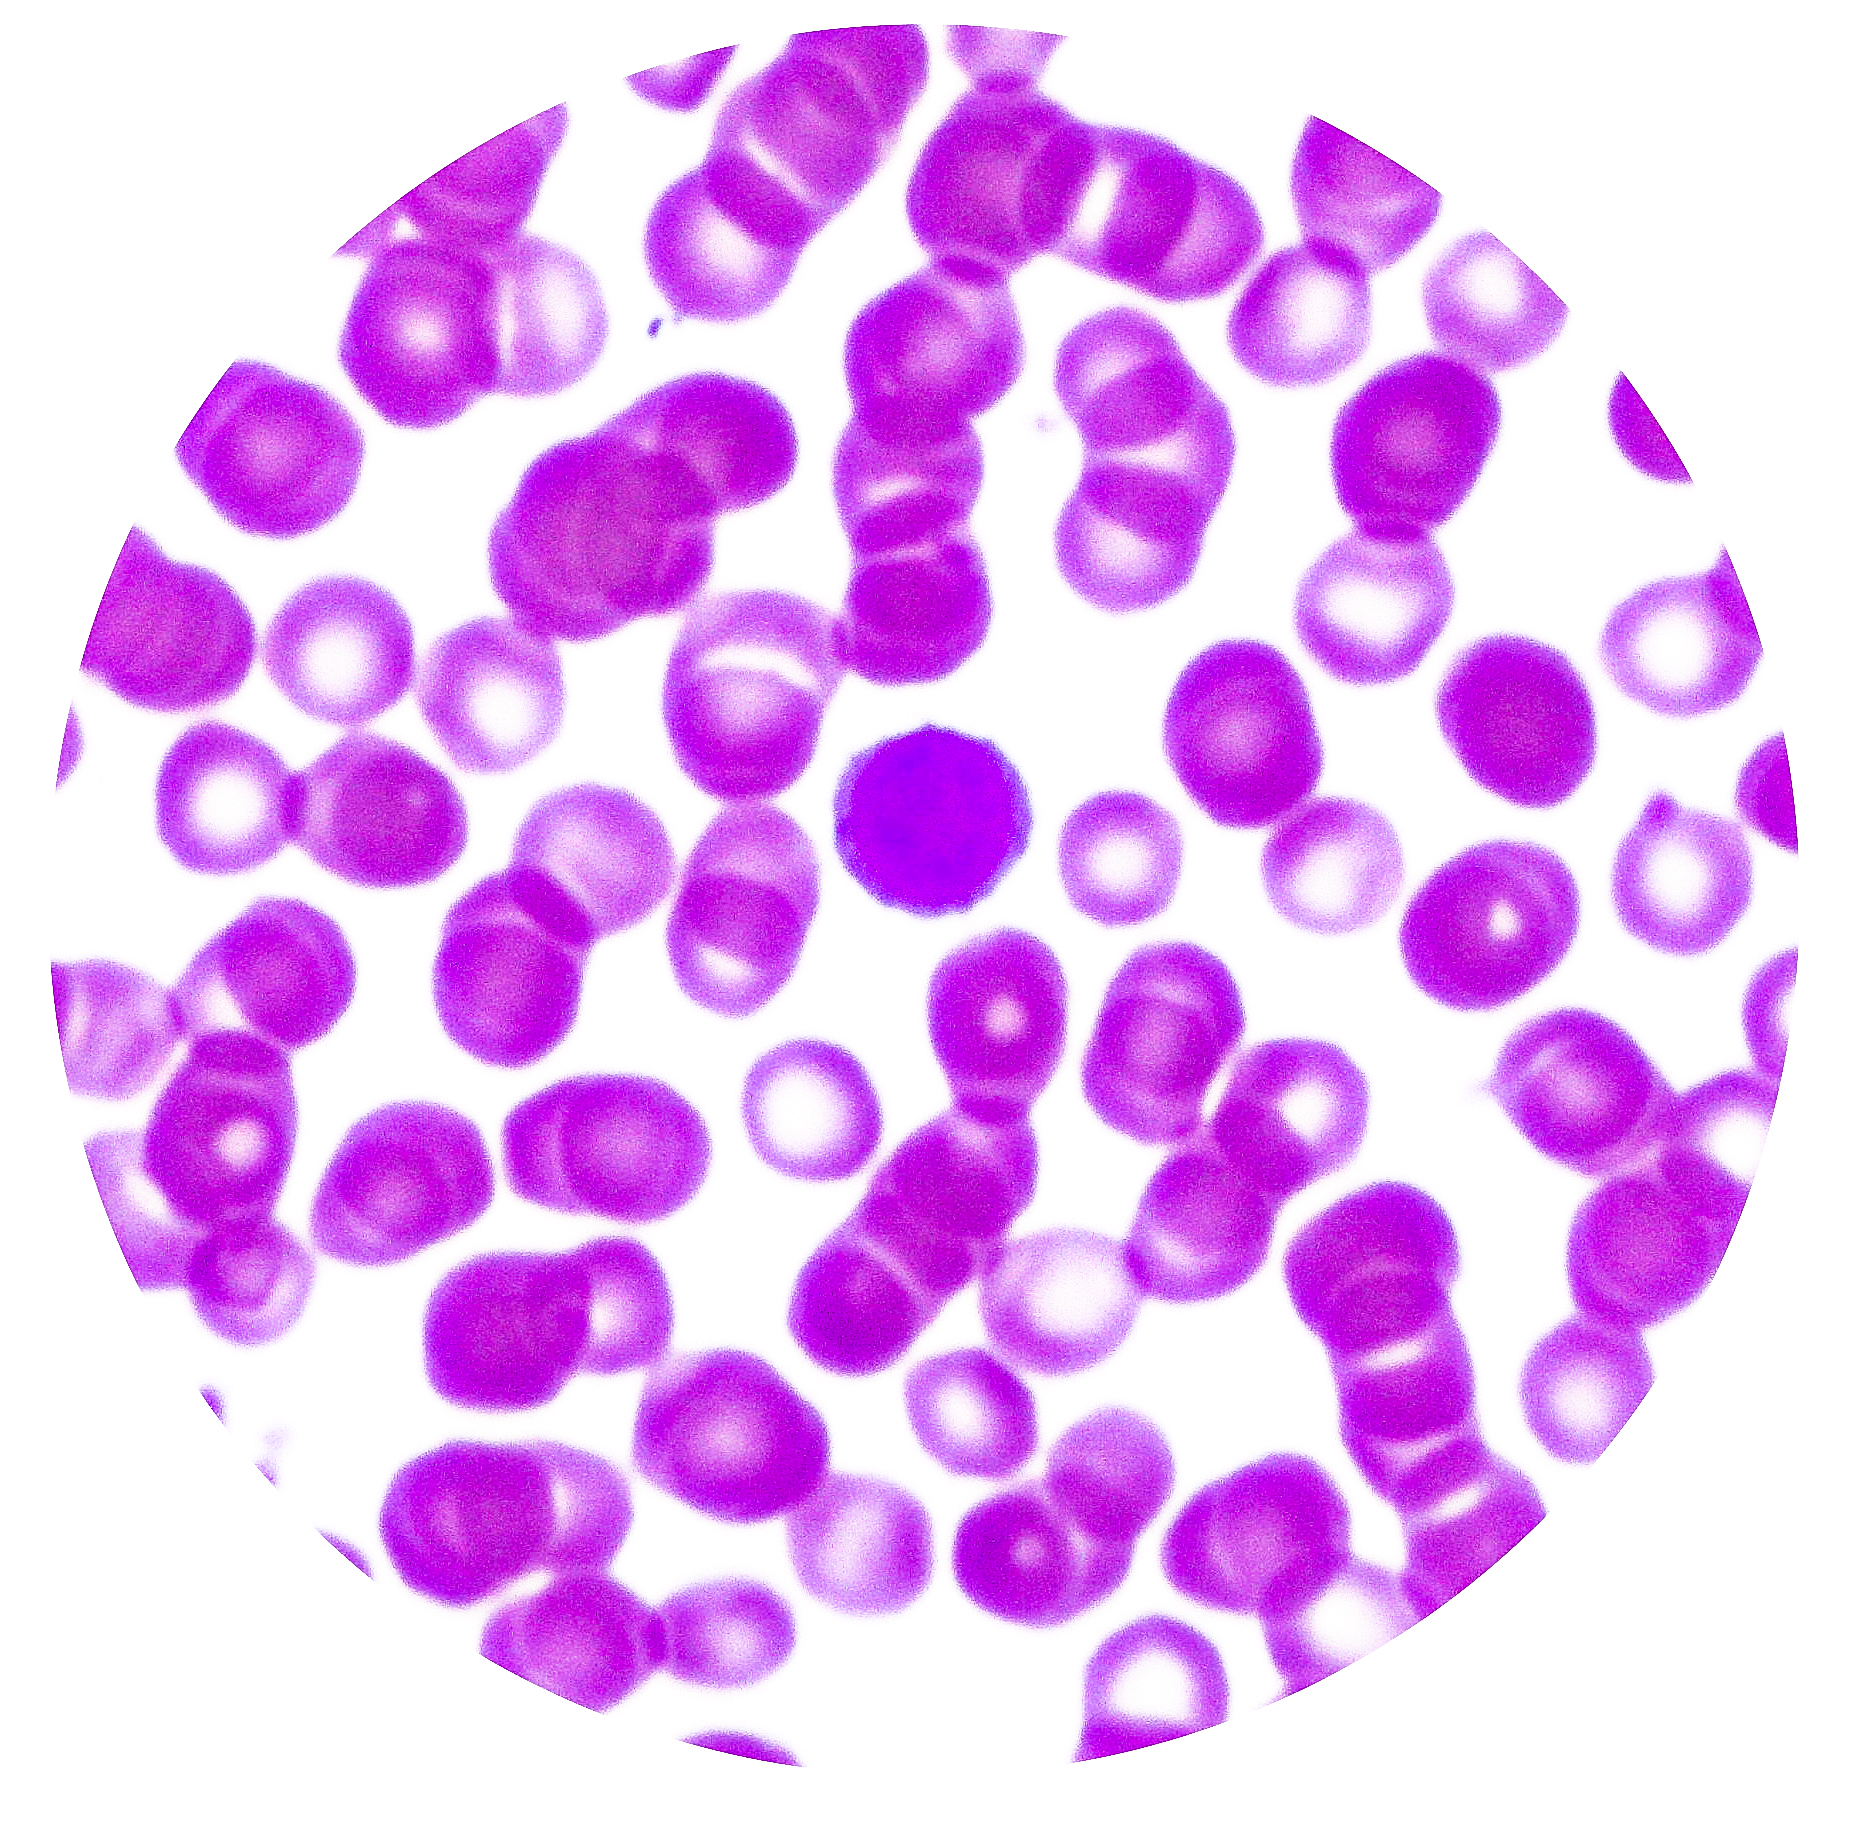

Tissues & Organs
Tissues & Organs
Blood Cells | KEY IDs
Erythrocytes (RBCs)
Shape | disc-shaped, oval
Nucleus | nucleated with the exception of mammals which are enucleated
Leukocytes
Granular Leukocytes
1. Neutrophils
Nucleus | horseshoe shaped, fragmented nucleus with 3-5 lobes
Granular Component | closely packed granules in cytoplasm
2. Eosinophils
Nucleus | bean/sausage shaped bilobed nucleus
Granular Component | cytoplasm contains dark red acidophilic granules
3. Basophils
Nucleus | S shaped, indented nucleus – usually masked by the staining of granules
Granular Component | many, large and dark stained granules
Agranular Leukocytes
4. Monocytes
Nucleus | large acentric, kidney or horseshoe shaped nucleus (with dent on the side)
Cytoplasm | small, less basophilic than a lymphocyte, contains azurophilic granules
5. Lymphocytes
Shape | round/ovalish cells, uniform in colour
Nucleus | clock-faces, spherical, deeply stained
Cytoplasm | basophilic
A. B Cells
Nucleus | round, oval, uniform
Differentiate into plasma cells (clock-face nucleus)
Function | Produce antibodies
B. T Cells
Function | immune function – Cytotoxic T cells, T helper cells, T Suppressor cells
6. Blood Platelets
Shape | small, irregularly shaped, disk shaped
Nucleus | non-nucleated cell fragments